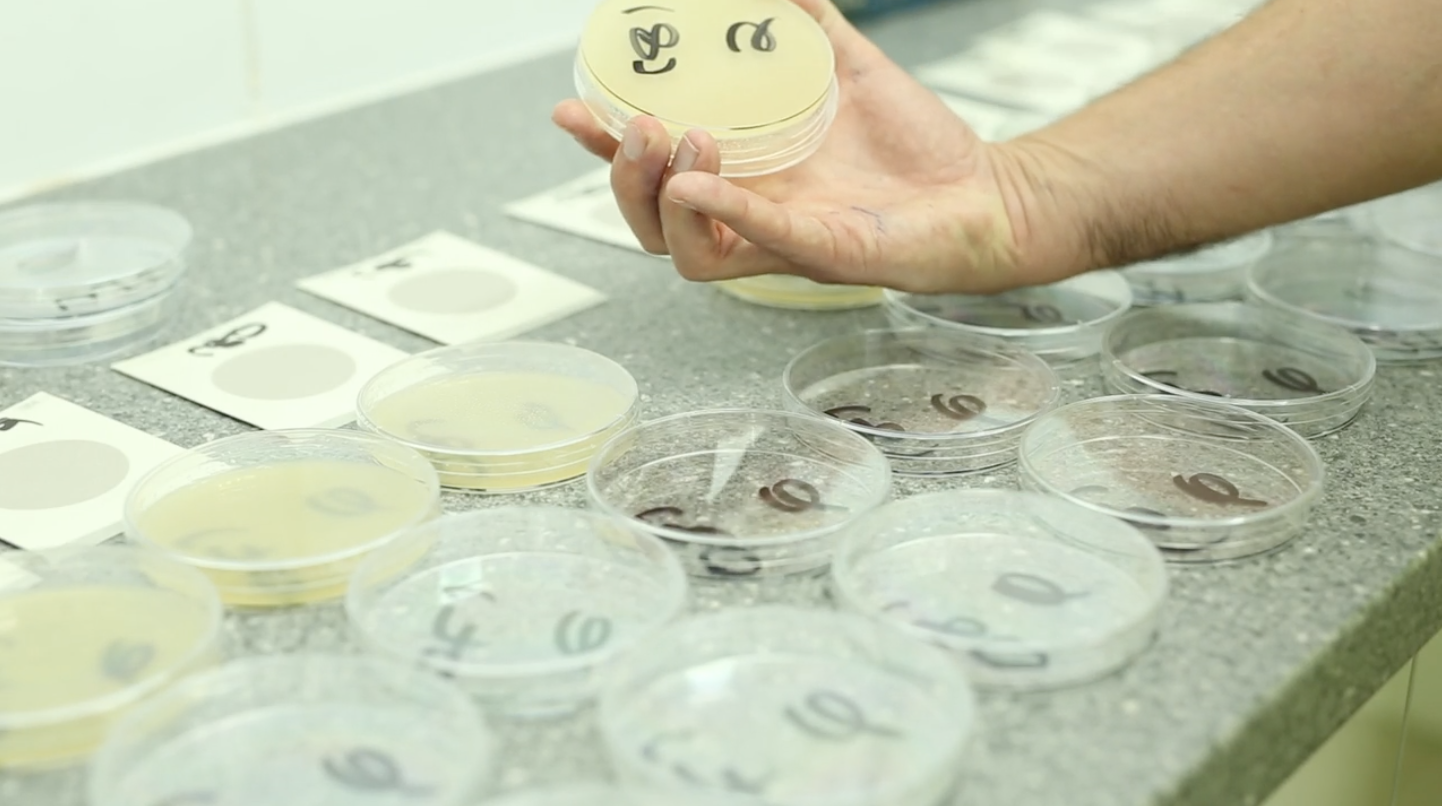

How We Make

We use the best quality milk
The milk we use to make our cheese comes from Belton Farm’s dedicated group of local dairy farmers who all farm within 25 miles of the dairy. Each pride themselves on the quality of their grass-fed, farm-assured milk and the health & welfare of their cows including ten with organic accreditations.
How We Make
Rigorous testing and traceability
Milk is collected from the farms on a daily basis by our tankers. When the milk arrives at the dairy a sample is taken by the laboratory and rigorously tested with full traceability being ensured at all times. Only once the milk has passed the tests is it pumped from the tanker to a milk storage silo ready for making into cheese.
How We Make

Handcrafted Cheese
The milk is pasteurised to kill any harmful micro-organisms and then cooled before being pumped into the cheese vats. The dairy’s five vats hold 14,500 litres each and it is here the starter culture is added to the milk to help start the ripening of the milk and the formation of the curds and whey.
How We Make

Handcrafted Cheese
Once the curd has ripened, vegetarian rennet is added to help coagulate and set the milk. The Cheesemaker then checks the curd has a firm set before starting to cut the curd. The curds and whey are then gently heated to various temperatures depending on the cheese variety, before being stirred, prior to pitching onto the curd table.
How We Make

Handcrafted Cheese
Once on the curd table the whey is gradually drained off and the curd is turned to help release any remaining whey. After each turn the acidity is tested by the Cheesemaker to check that it is increasing at a steady rate.
How We Make

Handcrafted Cheese
When the correct acidity is reached, the curd is then salted by hand to stop any further acidification.
How We Make

Handcrafted Cheese
The curd is then pushed into a vertical auger at the end of the curd table, through a peg or pin mill (depending on the variety of cheese being made).
How We Make

Handcrafted Cheese
The milled curd is then weighed and packed into either 20kg block, 12kg traditional, 6kg top hat or 4kg wheel moulds.
How We Make

Handcrafted Cheese
The mould is lined with a disposable cheesecloth to protect and seal the cheese, allow drainage and prevent the cheese sticking to the mould.
How We Make

Handcrafted Cheese
The filled moulds are placed into a press to help exude any remaining whey held by the curd. Belton Farm still make cheese using curd tables and pressing in the traditional way which can take anything up to 18 hours - this is more time consuming and labour intensive but gives much better results.
How We Make

Handcrafted Cheese
The moulds are taken out of the press the following morning and the cheese is knocked out of the mould. The cheese then has the cloth removed before being visually inspected.
How We Make

Handcrafted Cheese
The cheese is placed in the shrink and drying tunnels. The packed cheese then goes through a metal detector before being weighed and labelled with information on variety, date of manufacture, vat number, best before date, enabling complete traceability back to the supplying farm if required.
How We Make

Handcrafted Cheese
During the maturing period the cheese will be graded by our own highly experienced cheese graders. Using a cheese iron made of stainless steel or gunmetal, a plug of cheese is taken by the grader who will firstly smell the cheese to ensure there are no off flavours and then check the colour and texture of the curd is correct.
How We Make

Handcrafted Cheese
Packed cheese is boxed, palletised and put into cold storage, where it is allowed to mature at a constant temperature of 8°C for up to 12 months before it is ready to be delivered to customers.